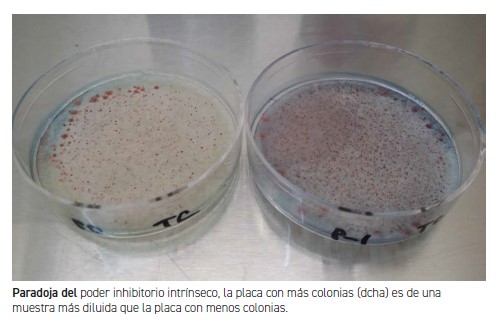
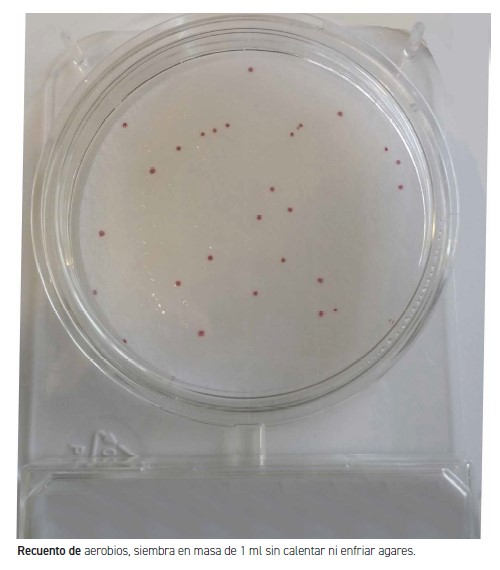

Tal y como sucede en microbiología de aguas, de ambientes (superficies y aire) y de alimentos, en microbiología cosmética hay una serie de puntos críticos muy graves que facilitan la obtención de resultados falsos (tanto falsamente positivos como falsamente negativos).
LA CIENCIA ES UNA SUCESIÓN DE ACONTECIMIENTOS que nos muestra cómo los errores son globalmente admitidos, hasta que alguien encuentra premisas adicionales, detecta que lo habitual es erróneo y tarda 50 o 100 años en que la comunidad científica acepte el error y respete al descubridor en vez de despreciarle o incluso quemarle en la hoguera. Vamos a repasar los puntos críticos más comunes en control microbiológico de cosméticos y cómo minimizarlos:
1. Compromiso entre la externalización de muestras y el autocontrol. Si externalizamos el 100% de muestras, perdemos la oportunidad de detectar los microorganismos que a menudo están presentes solo durante las primeras horas tras la fabricación del cosmético (gracias a la acción de los conservantes), ya que las muestras externalizadas empiezan a analizarse como pronto 24h tras su fabricación. Esto contradice gravemente las normas de correcta fabricación (GMPs). Pero si autocontrolamos el 100% de las muestras, sin tener la rutina de enviar ninguna a laboratorios externos, perdemos la oportunidad de un punto de vista alternativo al nuestro, que puede ser erróneo por cualquier motivo que no estamos detectando. Proponemos analizar un 100% de muestras en autocontrol y enviar un 10% a externalizar, aunque los pequeños fabricantes preferirán invertir estas proporciones. Pero analizar muestras de producto final no lo es todo. Las GMPs exigen el control de instalaciones, operarios y materias primas. La más crítica es el agua de producción, y un exclusivo recuento en R2A en aguas que no son de calidad farmacéutica, no garantiza su inocuidad, sobre todo teniendo en cuenta que las potabilizadoras no buscan ni están obligadas a buscar Pseudomonas aeruginosa ni Burkholderia cepacia complex, que son las dos graves fuentes de problemas en microbiología de las aguas de uso cosmético. Tanto agua, como instalaciones, como operarios, es más seguro autocontrolarlo que externalizarlo.

2. Creer que no encontrar un microorganismo en la muestra significa que no está presente en el lote, es el peor error de un análisis. Primero, porque una muestra de 1 g no es representativa del lote, dada la distribución ‘contagiosa’ de los microorganismos en cualquier muestra. En cambio, al menos 3 muestras de 10 g tomadas una al principio, otra en el medio y otra al final del lote, proporcionan muchísima menos incertidumbre en los resultados. Cada vez más normas ISO de microbiología no cosmética hablan de “no detectado” en vez de atrevernos temerariamente a afirmar “ausente”. Segundo, porque el único responsable legal de haber calculado correctamente el tamaño representativo de muestra de un lote que debe analizarse, es el fabricante.
3. Darle tanto valor a los indicadores “Recuento de aerobios” y “Recuento de hongos” como vemos que hacen muchos laboratorios, atreviéndose a analizar los patógenos solo si aparece alguna colonia en los recuentos totales, es una nefasta práctica que puede acarrear serios disgustos. Primero, porque los recuentos de aerobios no abarcan todas las poblaciones bacterianas, máxime cuando casi todo el mundo los analiza solo a la temperatura de los patógenos (olvidando una muestra duplicada a 25ºC para buscar bacterias saprófitas alterativas que, desde luego, tampoco crecerán en los medios para hongos). Segundo, porque lo que exigen la Ley General de Sanidad, el Reglamento Europeo 1223/2009 y las GMPs (ISO 22716) no es tener recuentos de menos de 1000 o de 100 ufc/g, sino la inocuidad del cosmético para la salud del consumidor (la ausencia de patógenos), y eso nadie puede garantizarlo con un simple recuento “0 ufc” en 0,1 g de muestra, que es la cantidad máxima de muestra que realmente se analiza en un recuento (aún menos si se usan placas preparadas de TSA y SDA, que solo absorben 0,1-0,3 ml de la dilución (-1), es decir, 0,01-0,03 g de muestra). Volveremos a este tema de las muestras inferiores al mínimo, cuando repasemos la detección de patógenos.
4. El uso de un adecuado caldo neutralizante de los conservantes es el punto crítico más importante de todos los que veremos. Tanto en los 30 minutos antes de los recuentos de aerobios y de hongos, como en las 18-36 horas de enriquecimiento previo a las estrías en agares de aislamiento, en la búsqueda de patógenos. Ya que vamos a buscar tanto bacterias como hongos, dicho caldo debe tener componentes adecuados para ambos grupos de microorganismos. Lamentablemente, la mayoría de caldos neutralizantes comerciales no están formulados para este doble propósito (e incluso llevan componentes ilegales por su toxicidad para el analista), llevando a constantes falsos negativos de levaduras como Candida albicans y de mohos como Aspergillus spp.
5. Además, el elevado poder inhibitorio intrínseco que tiene una gran proporción de cosméticos, nos muestra la ‘paradoja’ de que, a menudo, los patógenos se detectan mucho mejor en la dilución 1:100 que en la dilución habitual 1:10, dando lugar esta última a menudo a los peligrosos falsos negativos de patógenos.
6. El uso de 10 g de muestra en 90 ml del caldo neutralizante, seguido del trasiego de 10 ml del caldo neutralizante a 90 ml de otro caldo de enriquecimiento, nos puede dar la falsa sensación de que analizamos 10 g, pero en realidad supone la búsqueda de los patógenos enriqueciendo solo 1 g de cosmético. ¿Es una muestra de 1 g, representativa de un lote de 1.000 L, es decir (asimilando la densidad del cosmético como si fuese la de agua, 1 g/ml), de 1.000.000 de gramos? Por supuesto que no. La raíz cúbica de 1.000 L son 10 L, no 1 g. La curva esfuerzo/captura debe ser razonable, ni tan baja como 1 g ni tan alta como 10.000 g (10 L). Qué menos que asumir 10 g en tres puntos del lote. Es decir, en vez de 1 g de cosmético en un tubo de 9 ml de un caldo neutralizante que además sirva de caldo de enriquecimiento, debemos analizar 10 g de cosmético en un frasco de 90 ml de ese caldo neutralizante que además sirve de caldo de enriquecimiento, triplicando al principio, a la mitad y al final del lote. E ideal, además, según el punto crítico 5), 1 g de cosmético en un frasco de 99 ml de ese caldo neutralizante que además sirve de caldo de enriquecimiento, triplicando al principio, a la mitad y al final del lote.
7. La incubación del caldo neutralizante y de enriquecimiento durante solo 18 horas es un grave error para la búsqueda de patógenos tan lentos como Staphylococcus aureus o Candida albicans, que necesitan 36-48 horas para replicarse de modo detectable, lo cual lleva a una enorme proporción de resultados falsamente negativos para estos dos microorganismos. Sobre todo si luego se estría solo 1 μl del caldo enriquecido (asas calibradas de 1 lambda), totalmente insuficiente en muchas ocasiones, en vez de 10 μl (asas calibradas de 10 lambdas). Hay laboratorios que en vez de estriar tras el enriquecimiento, siembran el caldo enriquecido en masa o por extensión Digralsky, sin ser conscientes de que las miles de ufcs en que hemos convertido una ufc inicial al enriquecer, se van a convertir en miles de microcolonias que a menudo no serán detectables en la placa por competencia por el sustrato (sea o no cromogénico).
8. Los medios de aislamiento en placa que están empleando la mayoría de laboratorios son medios selectivos diseñados para microbiología clínica (donde los microorganismos están todo lo contrario de estresados) y alimentaria (donde la microbiota acompañante es elevadísima). Pero las matrices cosméticas son muy diferentes: altamente inhibitorias, con microorganismos sumamente estresados, hasta letárgicos, ‘sin ganas’ de manifestarse en los medios de cultivo, máxime en medios selectivos; y con flora acompañante en bajísimas proporciones. Llevamos ya 2 décadas comprobando en intercomparación que la microbiología cosmética merece nuevos medios, no copiados de los que se diseñaron el siglo pasado para otros tipos de microbiología. Medios más diferenciales que selectivos, enzimáticos (cromogénicos) en vez de bioquímicos, creados teniendo en cuenta la idiosincrasia de la matriz cosmética. Quienes han participando en inters donde se comparan los medios de aislamiento empleados, saben que no se obtienen los mismos resultados empleando MacConkey/EMB Levine que usando MugPlus, por ejemplo, ni empleando Baird Parker que usando XStaph Agar, ni empleando OFPBL que usando BCPT cromogénico, ni empleando Sabouraud o Candi-Crom clínico que usando Biggy Agar, con numerosos resultados falsamente negativos para los medios indicados en primer lugar de cada pareja.
9. El concepto de inocuidad equivale a “ausencia de patógenos”, no a “ausencia de los 4 patógenos para los que se redactaron Normas ISO”, ni tampoco a “ausencia de los 5 patógenos cosméticos si incluimos Burkholderia cepacia”. Tampoco se trata de buscar todos los patógenos humanos, pero sí es razonable buscar todos los patógenos que ya han provocado retiradas de mercado reiteradas de productos cosméticos a nivel internacional. Es decir, no solo los 5 antedichos, sino además: coliformes patógenos como Serratia marcescens o Pluralibacter gergoviae (y no solo el pésimo indicador en cosméticos E.coli), Aspergillus spp. patógenos, Pseudomonas putida (y no solo P. aeruginosa), estafilococos coagulasa positivos (sean o no S.aureus), complejo Burkholderia cepacia (no solo la cepa tipo, también B.multivorans y B.cenocepacia), enterococos fecales, Salmonella spp.
10. Tratar de identificar/confirmar colonias con galerías bioquímicas o enzimáticas, creadas todas ellas para microbiología clínica, lleva a un 99% de errores en la identificación, porque la base de datos Bacdive es sumamente incompleta para microorganismos ambientales, que son los que encontramos en los cosméticos. Deben enviarse a identificación molecular, ya que la base de datos Genbank sí que está al día para microorganismos ambientales y nos proporcionan identificaciones de alta fiabilidad.
Este es el resumen del contenido del curso de ‘Destreza en microbiología cosmética’ que la pandemia abortó. Gracias a Industria Cosmética, lo podemos difundir un año después.
Artículo escrito por:
Jorge Sanchis Solera
Director técnico de laboratorios
,Microkit y KosmLab